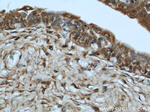
MYBPC1 Antibody in Immunohistochemistry (Paraffin) (IHC (P))

Search
Proteintech
MYBPC1 Polyclonal Antibody
{{$productOrderCtrl.translations['antibody.pdp.commerceCard.promotion.promotions']}}
{{$productOrderCtrl.translations['antibody.pdp.commerceCard.promotion.viewpromo']}}
{{$productOrderCtrl.translations['antibody.pdp.commerceCard.promotion.promocode']}}: {{promo.promoCode}} {{promo.promoTitle}} {{promo.promoDescription}}. {{$productOrderCtrl.translations['antibody.pdp.commerceCard.promotion.learnmore']}}
产品信息
22900-1-AP
种属反应
已发表种属
宿主/亚型
分类
类型
抗原
偶联物
形式
浓度
规格
纯化类型
保存液
内含物
保存条件
运输条件
产品详细信息
This antibody is specific to MYBPC1.
靶标信息
Myosin binding protein C (MYBPC) is a component of the thick filament of striated muscle, with the slow-type isoform designated MYBPC1. Both the fast-type (MYBPC2) and slow-type MYBPC protein contains seven immunoglobulin C2 motifs and three fibronectin type-III repeats. Multiple isoforms of MYBPC1 are known to exist, and are present in varying amounts in different skeletal muscles. It is thought that the MYBPC1 slow subfamily may play important roles in the assembly and stabilization of sarcomeric M- and A-bands and regulate the contractile properties of the actomyosin filaments.
仅用于科研。不用于诊断过程。未经明确授权不得转售。
生物信息学
蛋白别名: C-protein, skeletal muscle slow isoform; muscle C-protein; MyBP-C slow; myosin binding protein C, slow type; Myosin-binding protein C, slow-type; skeletal muscle C-protein; Slow MyBP-C; slow skeletal-type muscle myosin-binding-protein C; Slow-type C-protein; unnamed protein product
基因别名: 8030451F13Rik; CMYO16; CMYP16; LCCS4; MYBPC1; MYBPCC; MYBPCS; MYOTREM; ssMyBP-C
UniProt ID: (Human) Q00872, (Rat) Q63518
Entrez Gene ID: (Human) 4604, (Mouse) 109272, (Rat) 362867